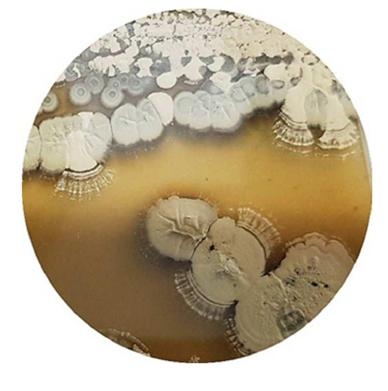

R&D 소재 개발 착수
미래기술융합제품혁신지원 사업은 충북청주 강소연구개발특구에서 진행하는 사업으로, 미래 신산업 대응을 위해 공공연구기관의 연구역량을 활용하여 기술 업그레이드, 스케일 업, 신제품 개발 등의 제품혁신을 지원한다.
이투바이오는 이화여자대학교 산학협력단으로부터 도입한 ‘안트라닐산을 유효성분으로 하는 피부 미백용 조성물’ 특허기술의 기술고도화 및 제품화를 목표로 해당 사업에 참여한다.
특허기술 개발자인 이화여대 약학과 임경민 교수, 자연과학대학 남상집 교수가 직접 과제 책임자로 참여한다는 점도 눈길을 끈다. 연구기술인 안트라닐산은 해양퇴적토에서 분리한 미생물 중 해양 방선균(Marine Sterptomyces) 및 해양 바실러스(Marine Bacillus )로부터 추출 및 분리된 천연소재이다.
색소 침착, 기미 등의 주요 원인인 멜라닌의 생성 저해도 측정 결과, 대표적 미백물질인 ‘알부틴’보다 약 3배 높은 멜라닌 생성 억제 능력을 보이며 피부 색소 침착과 관련된 피부 미백 치료제, 화장품, 의약품 등에 적용 가능함을 확인하였다(그림3). 기존 미백제의 제형 불안정 등의 문제점까지 보완하며 차세대 미백 기능성 물질로 주목받고 있다.
이투바이오는 국내 생물자원 기반 기술을 바탕으로 고가의 해외 수입 화장품을 대체하고자 하는 목표로 설립한 신생회사로, 미백기능성물질 조성 특허 기술을 활용하여 독자적이고 주도적인 연구 활동을 진행 중에 있다. 특히 올해 10월 초 청주 강소특구에 연구소기업 등록을 완료하며, 기술력을 인정받고 본격적인 화장품 원료 개발에 나섰다.
이투바이오 김수진 대표는 " 기능성 미백화장품 개발을 위해 이화여대로부터 도입한 특허기술에 대한 본격적인 원료개발을 시작하게 되어 기쁘게 생각하며, 과학적 검증을 통해 기능성을 인정받는 동시에 고객에게 편안하게 다가갈 수 있는 프리미엄 브랜드로 성장시키는 것을 목표로 하고 있다"고 말했다.
news@beyondpost.co.kr






















